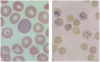
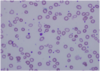
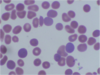
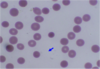
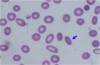
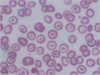
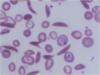
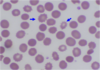
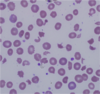
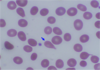
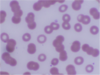
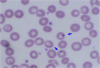
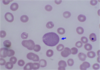
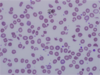
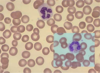
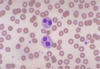
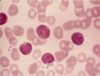
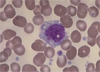
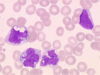
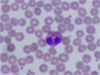

hematology Flashcards
(226 cards)
lifespan of blood cells
o Erythrocytes=120d
o Granulocytes=0.5d
o Platelets=9d
sites of hematopoeisis throughout the lifespan
o Prenatal: yolk sac
o 4months gestation—birth: liver, spleen
o Childhood: bone marrow (all over, incl tibia/femur)
o Adult: bone marrow shifts to vertebrae, sternum, and ribs predominantly
o *w/ inc. demand for blood cells, hematopoeisis can persist or be reestablished in normally inactive marrow sites (even liver/spleen)
bone marrow architecture
o Cords (niches)
• Mixture of cell types in various stages of maturation
o Sinuses
o Bone marrow-blood barrier
o Adipose and fibroblast cells and their secretions (adhesive molecules and chemokines, like CXCL12) provide the special microenvironment that allow HSC to survive (homing)
3 requirements for hematopoiesis
o Stem cells
o Stroma/extra-cellular matrix (microenvironment)
o Growth factors (regulators)
growth factors in hematopoiesis
o Stem cells (stem cell factor factors)
o Myeloid cells (GM-CSF, G-CSF, M-CSF)
o Erythroid cells (erythropoietin)—epo synthesized by kidney cells in response to hypoxia
o Megakaryocytes (thrombopoietin)
o Lymphoid cells (interleukins, cytokines)
o Growth factors (except EPO) exhibit redundancy (overlappin functions), pleiotrophy (multiple functions; stimulate multiple cells), and synergy (combo are more effective than individual factors)
o Synthesis is high localized w/ GF tethering
o Myeloid GF influence primitive progenitor cells and mature progeny
o Act to: maintain cell viability, initiate cell cycle, activate effector functions
hematopoietic stem cells
o Multi-potent (produce all different cell lines and possible endothelial cells)
o Self-renewing (can maintain its own cell pool)
- Asymmetric vs symmetric
o Capable of repopulating (bone marrow transplant)
o Capable of differentiation into mature precursors
o Are present in very low numbers and are morphologically indistinct
o Capable of mobility and redistribution through the circulation
red cell maturation
o Normally 50,000 in circulation
o If have severe RBC deficiency, can lose 1g Hb/week
o Decrease in cell size
o Decreasing nuclear-cytoplasmic ratio
o Nuclear maturation (chromatin clumping and extrusion)
o Cytoplasmic maturation (hemoglobin)
erythrocyte characteristics
o Non-nucleated biconcave disc
o Slightly smaller than normal lymphocyte nucleus
o Central pallor (1/3 cell diameter)
o Released into blood as reticulocytes
o 120 day lifespan (1/120 replaced every day = 0.8-1.0 % reticulocytes)
o main function is oxygen transport. Hemoglobins:
• Hb A (a2b2)—main adult hemoglobin (95%)
• Hb F (a2g2)—1% (but main Hb in fetuses)
• Hb A2 (a2d2)—2-3%
reticulocyte characteristics
o Newly produced red cells
o Slightly larger, diffusely basophilic cytoplasm
o Supra-vital staining of RNA-ribosomal complexes (still hemoglobin synthesis)
o Increased numbers reflect increased production. Markedly increased in hemolytic processes
erythropoietin
• Erythropoietin (EPO) is main regulator of RBC production:
o Made by interstitial cortical renal cells
o HIF (hypoxia inducible factor) regulates Epo txn
o Clinical uses:
• Anemia of renal failure
• Anemia of prematurity
• Myelodysplasia (refractory anemia, sideroblastic anemia)
• Anemia of chronic disease (inflammatory or malignant)
• w/ surgical procedures (autologous transfusion)
Lab values: RBC
• RBC – Total number
o Reported as number of cells per liter of blood
o Adult male 4.5-6 x1012/L, adult female 4-5.5 x1012/L
Lab values Hemoglobin
• Hemoglobin (Hb) – Concentration
o Measured as gram per deciliter of blood
o Adult male 14-18g/dL, Adult female 12-16g/dL
o Anemia: decreased Hb
o Polycythemia: increased Hb
Hematocrit Lab values
• Hematocrit (Hct) – Volume
o Volume of red blood cells to volume of whole blood cells
o Calculated from RBC and MCV: Hematocrit = RBC (cells/liter) X MCV (liter/cell)
o Adult male 40%-54%, adult female 35%-47%
Mean copuscular volume (MCV)
• Mean corpuscular volume (MCV)
o Determined as mean of red blood cell distribution histogram, Normal range: 82-100 um3
o Microcytosis: decreased MCV
o Macrocytosis: increased MCV
MCH lab value
• Mean corpuscular hemoglobin (MCH)
o Hemoglobin concentration per cell
o Normal range: 27-34 pg
o Hemoglobin divided by RBC
o Limited clinical use
MCHC lab values
• Mean corpuscular hemoglobin concentration (MCHC)
o Average hemoglobin concentration per total red blood cell volume, Normal range 32-36%
o Hemoglobin divided by hematocrit
o Limited clinical use
RDW lab values
• RDW: Red cell distribution width:
o Coefficient of variation of red cell histogram distribution curve
o Measure degree of variation of red blood cell size (or anisocytosis)
o Normal range: 11-15%
o Increase of RDW is associated with anemia from various deficiencies: Iron, B12, folate
o Normal or low RDW is associated with thalassemia or anemia of chronic disease
o Not specific, must be interpreted in conjunction of other CBC and red cell indices
lab values reticulocytes
• Reticulocytes:
o Immature red blood cells containing residual ribosomes
o Indicator of red cell production
o Normal range: 0.5-1.5% (20-76 B/L)
o Clinically used to evaluate anemia
• Low reticulocyte count: iron deficiency, folate/B12 deficiency, bone marrow failure
• High reticulocyte count: acute blood loss, hemolysis
ESR lab values
o Measures distance of red blood cells fall in a vertical tube over a given period of time
o Normal range: 0-15 mm/hr
o Negative charges on red blood cells prevent stacking
o Inflammatory proteins (such as fibrinogen, a-, b-, g-globins) increase red cell sedimentation.
o A more rapid fall of red cells in the test tube, resulting higher stack of red cells – elevated ESR
o Elevated ESR indicates inflammatory process
• useful in monitor disease process, esp. temporal arteritis, polymyalgia rheumatica
o Not recommended for screening test or diagnostic purpose
o False positive and false negative common
MCV low, RDW normal
thalassemia trait
MCV low, RDW high
iron deficiency
MCV normal, RDW normal
chronic disease
MCV normal, RDW high
homozygous hemoglobinopathy
MCV high, RDW normal
aplastic anemia